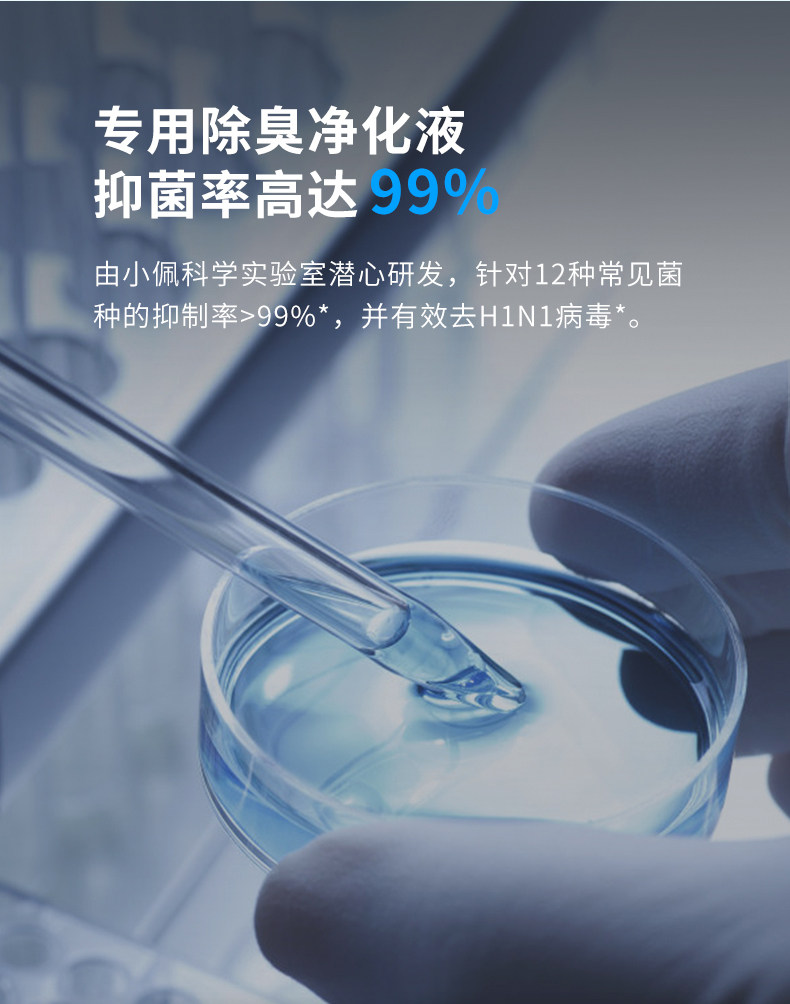

小佩智能喷雾净味器 猫砂盆除味剂猫砂除臭剂猫咪除臭机器
Link to the original- 100 — 1999 шт 5000$ per piece.
- 2000 — 50119 шт 4000$ per piece.
- 50120+ шт 3000$ per piece.
Inspection + photo report for $1.5.
We check the goods and take a photo report so you can make sure you get the right product without faults or damage
Delivery from China to Ukraine, Uzbekistan, European and African countries
Payable upon arrival at the warehouse in China
Returns are only possible while the item is in our warehouse in China. Once the goods have been dispatched from China, they cannot be returned
Photo and product description